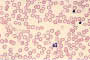
thalassaemia blood

| |

Cooley's anemia or thalassaemia major was first
described in 1925 by the American pediatrician Thomas Cooley.

The name thalassaemia was coined by the Nobel Prize-winning pathologist
George Whipple and the professor of pediatrics William Bradford.
It derives from the Greek thalassa (sea) and -aemia (blood).
Thalassaemia means "sea in the blood."

The gene for beta thalassaemia is relatively more frequent
in the Mediterranean. Because of this, thalassaemia major
has been called Mediterranean anemia.
|
|
|
| |
| Research
at PRI |
|
The main research
topic in the published literature of PRI is the new iron
chelating drug Deferiprone (L1),
which was discovered by G. J. Kontoghiorghes and is used
worldwide in thalassaemia and other conditions of
transfusional iron overload. Click on the
following links to see
the
history of Deferiprone and recent
related publications.
Relevant institute studies have been published in
international journals. Click
here for details.
The
main areas of research interest and activity at the Postgraduate Research Institute
include:
Medicine
Thalassaemia and other Haematological conditions
Nuclear Medicine
Psychiatric conditions
Metal toxicities
Metal deficiencies
Ethics
Biochemistry
Metal Biochemistry
Proteins in the transport and storage of metal
ions
Free Radicals
Antioxidants
Chemistry
Synthetic chemistry
Medicinal chemistry
Inorganic chemistry
Pharmacology
Pharmacokinetics
Drug metabolism
Pharmaceuticals
Drug design and development
Metal chelating drugs
Orphan Drugs
Diagnostics
Environment
Hydrotechnology
Water treatment
Environmental pollution
Nutrition
All aspects
|
|
|
| |
|
Best viewed
with
Internet Explorer
at 800 x 600 or higher
Last update:
24 January 2006
|
|
|
|
|
|